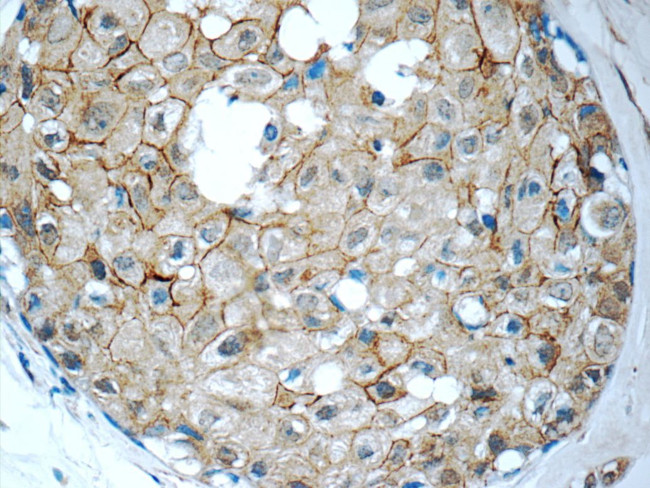
ALCAM Antibody in Immunohistochemistry (Paraffin) (IHC (P))
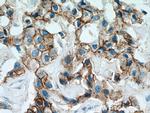
ALCAM Antibody in Immunohistochemistry (Paraffin) (IHC (P))

Search
Proteintech
ALCAM Polyclonal Antibody
{{$productOrderCtrl.translations['antibody.pdp.commerceCard.promotion.promotions']}}
{{$productOrderCtrl.translations['antibody.pdp.commerceCard.promotion.viewpromo']}}
{{$productOrderCtrl.translations['antibody.pdp.commerceCard.promotion.promocode']}}: {{promo.promoCode}} {{promo.promoTitle}} {{promo.promoDescription}}. {{$productOrderCtrl.translations['antibody.pdp.commerceCard.promotion.learnmore']}}
产品信息
21972-1-AP
种属反应
宿主/亚型
分类
类型
抗原
偶联物
形式
浓度
规格
纯化类型
保存液
内含物
保存条件
运输条件
产品详细信息
Immunogen sequence: WYTVNSAYG DTIIIPCRLD VPQNLMFGKW KYEKPDGSPV FIAFRSSTKK SVQYDDVPEY KDRLNLSENY TLSISNARIS DEKRFVCMLV TEDNVFEAPT IVKVFKQPSK PEIVSKALFL ETEQLKKLGD CISEDSYPDG NITWYRNGKV LHPLEGAVVI IFKKEMDPVT QLYTMTSTLE YKTTKADIQM PFTCSVTYYG PSGQKTIHSE QAVFDIYYPT EQVTIQVLPP KNAIKEGDNI TLKCLGNGNP PPEEFLFYLP GQPEGIRSSN TYTLTDVRRN ATGDYKCSLI DKKSMIASTA ITVHYLDLSL NPSGEVTRQI GDALPVSCTI SASRNATVVW MKDNIRLRSS PSFSSLHYQD AGNYVCETAL QEVE (28-400 aa encoded by BC137097)
靶标信息
This gene encodes activated leukocyte cell adhesion molecule (ALCAM), also known as CD166 (cluster of differentiation 166), which is a member of a subfamily of immunoglobulin receptors with five immunoglobulin-like domains (VVC2C2C2) in the extracellular domain. This protein binds to T-cell differentiation antigene CD6, and is implicated in the processes of cell adhesion and migration. Multiple alternatively spliced transcript variants encoding different isoforms have been found.
仅用于科研。不用于诊断过程。未经明确授权不得转售。
生物信息学
蛋白别名: Activated leukocyte cell adhesion molecule; ALCAM/CD166; BEN; CD166; CD166 antigen; FLJ38514; MGC71733; Protein DM-GRASP; unnamed protein product
基因别名: AI853494; ALCAM; BEN; CD166; DM-GRASP; MEMD; MuSC; SC1
UniProt ID: (Human) Q13740, (Mouse) Q61490
Entrez Gene ID: (Human) 214, (Mouse) 11658